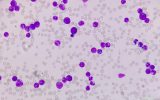

14 декабря
13 декабря
-
18:33
Прорыв в термоядерной энергетике: впервые получили больше энергии, чем потратили
 Наука
Наука
-
17:57
25 дней полета лунного корабля «Орион» показали в одном видео
 Космос
Космос
-
16:33
Разработан имплантируемый «вентилятор», который помогает дышать
 Наука
Наука
-
15:59
Производство водородного топлива ускорили в 14 раз с помощью звука
 Новости
Новости
-
15:26
Посмотрите на фото Земли из космоса: его сделал первый частный модуль
 Космос
Космос
-
13:30
Звездный поток Геминид прольется на Землю в декабре: где и как смотреть
 Кейсы
Кейсы
12 декабря
-
14:44
Крупнейшую в мире волновую электростанцию построят на Черном море
 Новости
Новости
-
14:08
Прекрасно сохранившийся средневековый корабль нашли в Норвегии
 Наука
Наука
-
13:29
В Китае тестируют гиперзвуковой запуск космических ракет с трамплина
 Новости
Новости
-
12:36
Тяжелое течение COVID-19 ускоряет старение мозга
 COVID-19
COVID-19
-
11:47
Посмотрите на космическую «дымную стену» в объективе «Хаббла»
 Космос
Космос
-
11:10
Генетически модифицированные клетки привели к ремиссии рака крови
Наука
Наука
11 декабря
10 декабря
-
20:00
Финал миссии «Артемида-1»: как это будет, где смотреть и что дальше
 Кейсы
Кейсы
-
17:51
«Закрученный свет» может ускорить работу компьютеров в миллион раз
 Новости
Новости
-
16:32
Тонкая пленка превращает любую поверхность в солнечную батарею
 Новости
Новости
-
9:00
«Джеймс Уэбб» открыл четыре галактики ранней Вселенной
 Космос
Космос



